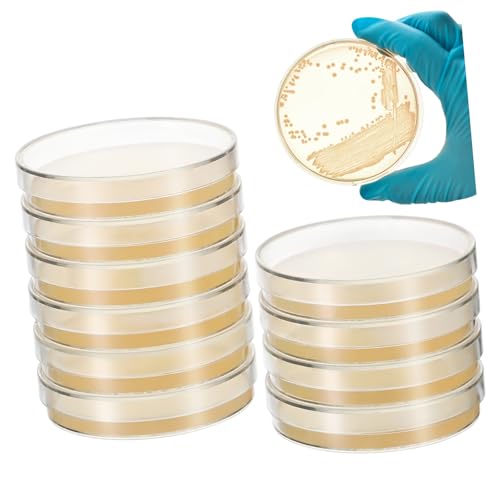
MUSISALY 10pcs Nutrient Agar Plates 7cm Petri Dishes Agar Plates Mycology Supplies

Product Information
Specification
Brand : MUSISALY
BulletPoint1 : Agar plates:this pre-poured agar science kit will engage your students, friends and siblings for a long time,prepoured agar plates
BulletPoint2 : Agar petri dishes:professional and practical design with beautiful appearance, easy to carry and use,agar plate
BulletPoint3 : Petri dish with agar:they have a thick layer of agar which promotes good growth, easy to use,pre poured agar petri dish
BulletPoint4 : Petri dishes with agar:these plates are the size for school-aged for use in science class,petri dish agar
BulletPoint5 : Agar plates mycology:used for a wide range of , including culture storage, isolation of pure cultures, or simply general culture,nutrient agar
Color : As Shown
ExternallyAssignedProductIdentifier : 7677730265608
ItemDisplayDimensions_Length : 2.76 inches
ItemDisplayWeight : 0.44 pounds
ItemName : MUSISALY 10pcs Nutrient Agar Plates 7cm Petri Dishes Agar Plates Mycology Supplies
ItemPackageDimensions_Height : 3.15 inches
ItemPackageDimensions_Length : 3.94 inches
ItemPackageDimensions_Width : 3.15 inches
ItemPackageQuantity : 1
ItemTypeKeyword : science-lab-petri-dishes
ItemVolume : 1 cubic_centimeters
Manufacturer : MUSISALY
Material : Agar
ModelNumber : IU12N1524YC89
NumberOfItems : 1
NumberOfLithiumMetalCells : 1
PartNumber : IU12N1524YC89
ProductDescription : Package Include
10 x Agar Plates
Features
-Color:As Shown laboratory supplies
-Size:7.00X7.00X1.00cm/2.75X2.75X0.39in prepoured agar plates
-Material:Agar prepoured petri dish
-Great to create fun science memorization while learning, and observing some cool science facts. agar petri dishes
-This pre-poured agar science kit will engage your students, friends and siblings for a long time agar plates for experiment.
-Professional and practical design with beautiful appearance, easy to carry and use. petri dish
-Used for a wide range of , including culture storage, isolation of pure cultures, or simply general culture prepoured petri plates.
-Fresh plates promote faster growth as compared to aged stored plates tissue culture agar plates.
Goods Description
telephone agar agar Our plates are pre-poured.nutrient agar agar Great for elementary, middle school and high school students.prepoured nutrient agar plates It is a set of agar plates, which are used for culture storage, isolation of pure cultures, or simply general culture.agar plate Don't waste time pouring agar
ProductSiteLaunchDate : 2024-11-26T05:03:54.879Z
Size : 7.00X7.00X1.00CM
SupplierDeclaredDgHzRegulation : not_applicable
UnitCount : 1
UnspscCode : 41000000